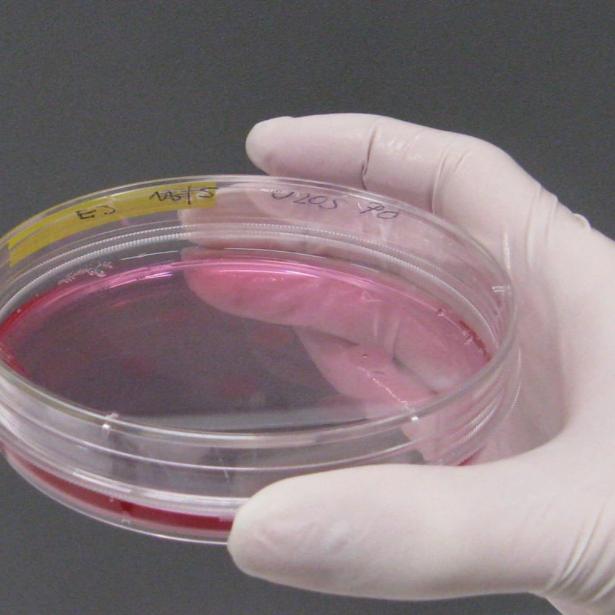
◳ 3_zivocisne bunecne kultury (jpg) → (ořez 215*215px)

Akademie mládeže
Vysoká škola chemicko-technologická v Praze a Stanice přírodovědců Domu dětí a mládeže hl. m. Prahy pořádají pro studenty gymnazií, odborných škol a pro ostatní zájemce Akademii mládeže.
58. ročník Akademie mládeže v roce 2025 - zimní semestr
Přednášky na atraktivní témata vědců z VŠCHT Praha.
Konají se vždy v úterý od 17 hodin v posluchárně BII budovy B Vysoké školy chemicko-technologické v Praze 6 –Dejvicích (ulice Technická 1903).
Na přednášky není nutná předchozí registrace a vstup na ně je zdarma.
Plánované
 7. října 2025 - Moderní trendy v cukrovarnické technologii
7. října 2025 - Moderní trendy v cukrovarnické technologii
doc. Ing. Svatopluk Henke, Ph.D. Ústav sacharidů a cereálií, FPBT
V posledních letech se setkáváme s řadou odlišných názorů jak na konzumaci cukru, tak na výrobu cukru v českých zemích. Jak je to vlastně se sacharosou neboli řepným či třtinovým cukrem z hlediska výroby, spotřeby a výživy? Je české cukrovarnictví srovnatelné se světovým? Během přednášky budou ukázány zajímavé historické a současné statistiky, třeba kde všude se cukrová řepa zpracovává na krystalový cukr a jaký je vztah mezi vývojem populace a spotřebou cukru. Moderní cukrovar není jen výroba cukru ale též výroba dalších vedlejších produktů jako je biolíh, sušené řízky, hnojiva či bioplyn. Současné cukrovarnictví navíc představuje příklad velmi efektivního oběhového hospodářství a ve finále se stává producentem nikoli spotřebitelem čisté vody.
 21. října 2025 - Bakterie na talíři: Probiotika obohacená selenem
21. října 2025 - Bakterie na talíři: Probiotika obohacená selenem
doc. Ing. Antonín Kaňa, Ph.D., Ústav analytické chemie, FCHI
Probiotika jsou známá svými příznivými účinky na lidské zdraví, ale co když je navíc obohatíme o esenciální stopový prvek – selen? Přednáška představí potenciál probiotických bakterií jako nosičů selenu a jejich uplatnění při výrobě funkčních potravin. Dozvíte se, jak lze tyto mikroorganismy cíleně kultivovat tak, aby efektivně akumulovaly selen ve formě biologicky dostupných sloučenin. Pozornost bude věnována také analytickým metodám, které umožňují sledovat a vyhodnocovat proces obohacování bakterií selenem.
4. listopadu 2025 - Živočišné buněčné kultury – od HeLa buněk k alternativám testů na zvířatech,
4. listopadu 2025 - Živočišné buněčné kultury – od HeLa buněk k alternativám testů na zvířatech,
Ing. Eva Jablonská, Ph.D., Ústav biochemie a mikrobiologie, FPBT
Ve 20. století se testování na zvířatech stalo běžnou metodou pro hodnocení bezpečnosti chemikálií, léčiv, kosmetiky i materiálů. Tyto testy však vyvolávají etické otázky a často ani neodrážejí reakce lidského těla. V posledních desetiletích proto vědci vyvíjejí moderní metody, které využívají lidské buněčné kultury v laboratorních podmínkách. První lidskou buněčnou kulturou byly HeLa buňky odebrané v Americe paní Henriettě Lacks. Od této průlomové události, která byla dokonce knižně i filmově zpracována, se buněčné kultury staly klíčovým nástrojem moderní biologie a medicíny. V přednášce se kromě příběhu HeLa buněk dozvíte, jak se s živočišnými buněčnými kulturami zachází a jak se používají například k testování biomateriálů.
 18.listopadu 2025 - Moderní lékové formy – od pilulek k nanočásticím
18.listopadu 2025 - Moderní lékové formy – od pilulek k nanočásticím
doc. Dr. rer. nat. Jarmila Zbytovská, Ústav organické technologie, FCHT
Jak se změnil způsob podávání léků od dob starověkých mastí a odvarů po dnešní vysoce sofistikované nanočástice? Přednáška vám ukáže, jak moderní farmaceutické technologie mění způsob, jakým léčiva působí v těle. Zaměříme se na lékové formy, které umožňují řízené uvolňování účinné látky a prodloužení jejího účinku, stejně jako na tzv. drug targeting – cílené doručování léčiv přímo na místo účinku pomocí nanotechnologií. Dozvíte se, proč není tableta jako tableta – a jak moderní přístupy mohou zefektivnit léčbu a snížit nežádoucí účinky.
2. prosince 2025 - Heterogenní katalyzátory – netradiční cesty k porozumění jejich vlastnostem,
Ing. Martin Veselý, Ph.D., Ústav organické technologie, FCHT
Jak zjistíme, co se děje na povrchu materiálu, který urychluje chemickou reakci, aniž by se sám spotřeboval? V této přednášce se podíváme do světa heterogenní katalýzy – klíčového oboru chemického průmyslu a ochrany životního prostředí. Zaměříme se na moderní metody, které nám umožňují studovat katalyzátory na různých úrovních, od atomární po katalytický reaktor jako celek.
 9. prosince 2025 - „Plasty: Od výroby přes každodenní život až po chytrou recyklaci – Objevte jejich fascinující svět!“
9. prosince 2025 - „Plasty: Od výroby přes každodenní život až po chytrou recyklaci – Objevte jejich fascinující svět!“
Ing. Petr Straka, Ph.D., Ústav udržitelných paliv a zelené chemie, FTOP
Plasty nás obklopují na každém kroku – ať už v obalech, medicíně, nebo high-tech průmyslu. Jejich celosvětová produkce v roce 2023 překročila 413 milionů tun a stále roste! Přijďte odhalit, jak se plasty vyrábějí, proč jsou tak nepostradatelné a jaké inovace mění jejich budoucnost. Prozkoumáme moderní technologie výroby, od ropných surovin po udržitelné alternativy, jako je biomasa či zachycený CO₂. Ponoříme se do světa recyklace a ukážeme, jak můžeme proměnit odpad v nové produkty. Tato přednáška vás inspiruje k zamyšlení nad tím, jak můžeme plasty využívat chytřeji a snížit jejich dopad na planetu!







